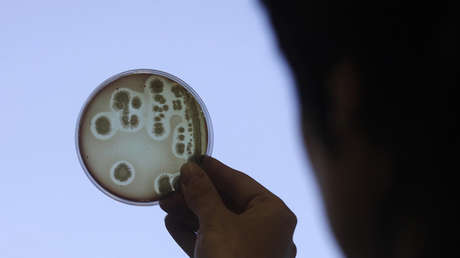
VIDEO: Captan el instante en el que una bacteria se apropia de ADN para acelerar su propia evolución

Un grupo de científicos de la Universidad de Indiana, EE.UU., ha publicado esta semana un video del preciso instante en que una bacteria Vibrio cholerae, causante de la enfermedad del cólera, se apropia de ADN con la finalidad de acelerar su propia evolución.
El descubrimiento de este proceso microscópico, inmortalizado por primera vez, podría resultar útil para combatir a las bacterias resistentes a los antibióticos. Por medio de un microscopio y gracias a un nuevo método de tinción (uso de colorantes en microorganismos para distinguir los procesos), los investigadores pudieron observar cómo uno de los apéndices de dicha bacteria —que es más de 10.000 veces más delgado que un cabello humano— extraen de su entorno fragmentos de ADN para incorporarlos al suyo propio. Este proceso se conoce bajo el nombre técnico de transferencia genética horizontal.
El grupo de científicos, que publicó este lunes los resultados de su hallazgo en la revista científica Nature Microbiology, utilizó un innovador método de tintado de los pili, que son estructuras en forma de pelo que se hallan en la superficie de la mayoría de bacterias, así como de los fragmentos de ADN circundantes, para observar el proceso llevado a cabo por la Vibrio cholerae. El hallazgo supone un punto de inflexión a la hora de entender el funcionamiento de dichas estructuras, ya que hasta ahora había resultado imposible observarlas debido a su diminuto tamaño.
Durante la transferencia horizontal de genes "la resistencia a los antibióticos se traslada entre especies bacterianas", un proceso que "nunca había sido observado antes", debido a que "las estructuras involucradas son increíblemente pequeñas", explicó este lunes el coautor Ankur Dalia, que es profesor adjunto en Biología en la Universidad de Indiana. "Cuanto más comprendamos cómo comparten ADN las bacterias, mayores posibilidades tendremos de contrarrestarlas", añadió Dalia.
Según demuestra el nuevo estudio, los pili son una herramienta fundamental a la hora de extraer ADN. La estructura en cuestión actúa como un arpón y penetra un poro de la pared bacteriana con el fin de alcanzar con su extremo el ADN y extraerlo para introducírselo a sí misma.
Esta revelación podría contribuir a conocer mejor este tipo de bacterias resistentes a los antibióticos, que, según el Centro para el Control y Prevención de Enfermedades de EE.UU., cada año afectan a alrededor de dos millones de personas solo en territorio estadounidense. Este tipo de cepas bacterianas fueron halladas en casi 500.000 personas que padecen tuberculosis.